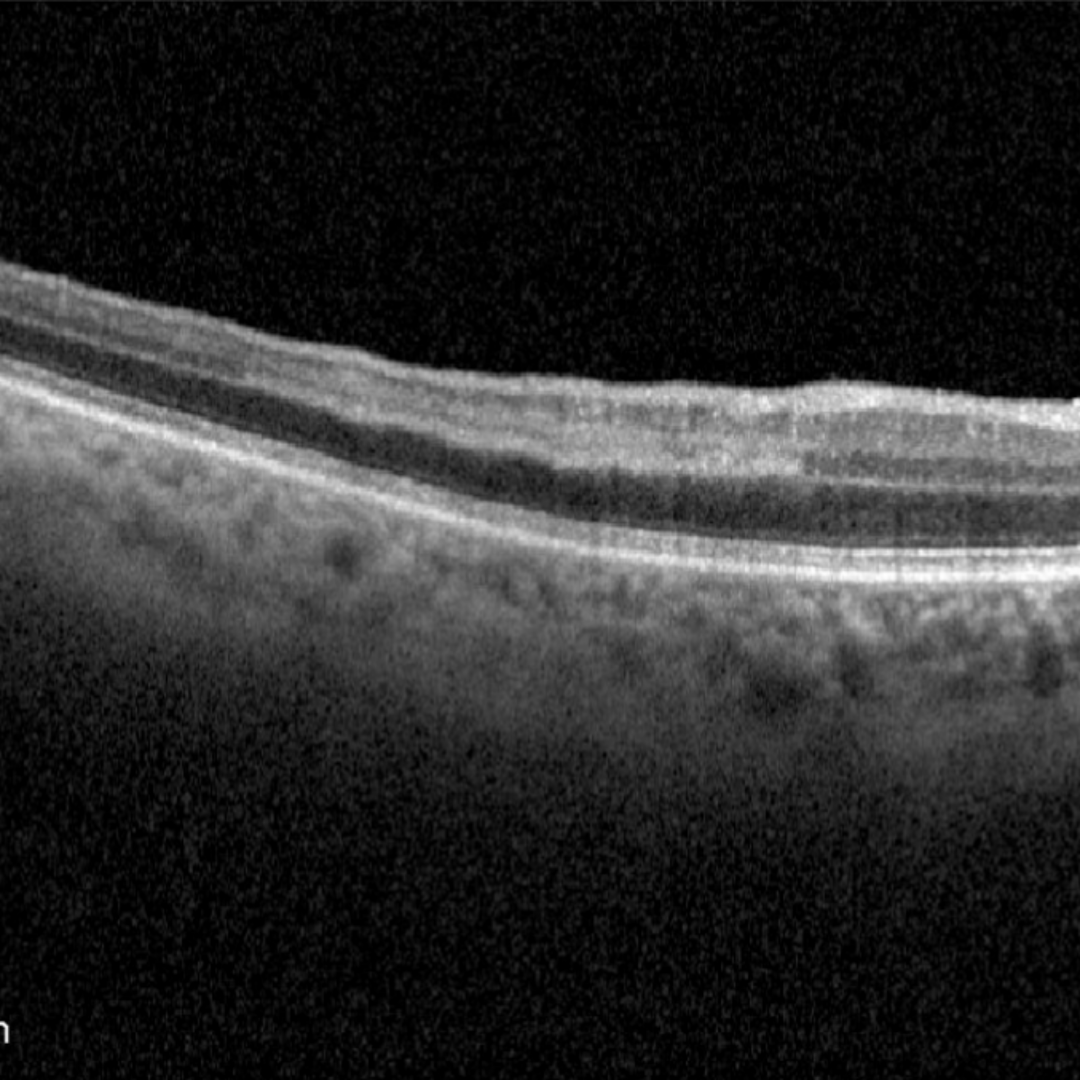

Overview
PAMM is an OCT-based clinical sign characterised by the presence of a hyper-reflective band within the inner nuclear layer (INL) of the retina which, over time, results in thinning of the INL without involvement of the outer retina. This finding is typically associated with a paracentral visual field defect and a hypo-reflective paracentral lesion on infra-red imaging.
The key differential for PAMM is acute macular neuroretinopathy (AMN) which is also associated with scotomas and hypo-reflective paracentral lesions on infra-red imaging. AMN however is characterised by hyper-reflectivity of the outer plexiform layer and inner nuclear layer on OCT. For more information on AMN, please use the link at the bottom of the page.
PAMM may be associated with a wide variety of systemic disorders (eg diabetes) and localised retinal vascular disease (eg retinal artery occlusion) and this sign reflects ischaemia in the deep vascular complex.
OCT angiography (OCTA) studies have shown that both PAMM and AMN lesions are associated with capillary vascular occlusions however the two conditions are though to affect different capillary plexuses.
Differential Diagnosis
References
Chu, S. Nesper, PL. Soetikno, BT. Bakri, SJ. Fawzi, AA, (2018) Projection-Resolved OCT Angiography of Microvascular Changes in Paracentral Acute Middle Maculopathy and Acute Macular Neuroretinopathy. Invest. Ophthalmol. Vis. Sci. 59(7):2913-2922.
Scharf, J. Bailey Freund, K. Sadda, SV. Sarraf, D. (2021) Paracentral acute middle maculopathy and the organization of the retinal capillary plexuses, Progress in Retinal and Eye Research, Volume 81, 100884.


